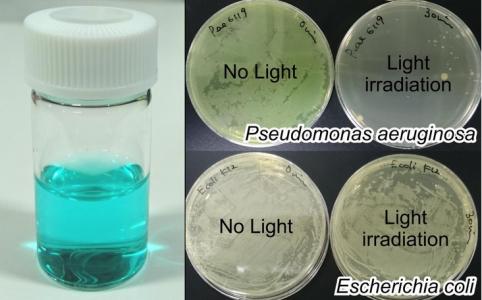
Cette nouvelle approche consiste à apporter directement à la bactérie un antimicrobien en piratant son mécanisme interne d'acquisition du fer dont elle a besoin pour survivre.

ANTIBIORÉSISTANCE : Ils piratent le mécanisme bactérien d'acquisition de l'hème
Cette équipe de l’Université de Nagoya a peut-être trouvé le moyen de venir à bout de la pharmaco-résistance des superbactéries, une menace croissante en santé publique, face au développement modeste de nouveaux antibiotiques. Cette nouvelle approche consiste à apporter directement à la bactérie un antimicrobien en piratant son mécanisme interne d'acquisition du fer dont elle a besoin pour survivre. Un véritable système de « cheval de Troie », présenté dans la revue ACS Chemical Biology et qui fait ses preuves, ici contre la terrible bactérie Pseudomonas aeruginosa.
Pseudomonas aeruginosa est une bactérie dangereuse qui provoque des infections (nosocomiales) en milieu hospitalier et chez les personnes dont le système immunitaire est affaibli. De nombreuses souches de la bactérie sont résistantes aux antibiotiques et donc mortelles. La bactérie peut causer des infections sanguines et une pneumonie. P. aeruginosa est l’un des agents pathogènes les plus critiques nécessitant d’urgence des stratégies alternatives, selon l’Organisation mondiale de la santé (OMS). Ici l’équipe japonaise montre que la bactérie peut être détruite en détournant son système de captage de l'hème afin de lui délivrer des antimicrobiens de manière sélective. Une stratégie qui vaudrait aussi pour d'autres bactéries.
Détourner un mécanisme d’acquisition de la bactérie pour « lui donner » des médicaments
Les bactéries ont besoin de fer et l’acquièrent via « le mécanisme d'acquisition de l'hème ». Cette bactérie comme de nombreux organismes a mis au point un système qui lui permet d’acquérir ce fer. Le fer est essentiel à la croissance et à la survie des bactéries, mais chez l'Homme, il est en grande partie retenu dans le complexe « hème » de l'hémoglobine, l’hème étant une structure contenant un atome de fer. Pour acquérir ce fer, P. aeruginosa (et d'autres bactéries) sécrètent une protéine appelée HasA, qui se verrouille dans l'hème dans le sang. Ce complexe est reconnu par un récepteur membranaire sur la bactérie, appelé HasR, qui permet l'entrée de l'hème dans la cellule bactérienne, puis HasA est recyclé pour en extraire encore davantage.
Détourner ce système d’acquisition de l’hème pour délivrer un antibactérien, directement à la bactérie : les scientifiques ont développé une poudre constituée de HasA et du pigment gallium phtalocyanine (GaPc), consommée par les bactéries. Ce point est validé in vitro dans une culture de P. aeruginosa. Lorsque la poudre est exposée à la lumière infrarouge, des espèces d'oxygène réactif (ROS) nuisibles sont générées à l'intérieur des cellules bactériennes : 99,99% des bactéries sont détruites après 10 minutes d’irradiation.
Une stratégie efficace sur d’autres bactéries : la stratégie fonctionne sur toutes les bactéries avec récepteur HasR sur leurs membranes. De plus, le système d'acquisition de l'hème étant essentiel à la survie de ces bactéries, il est peu probable, indiquent les chercheurs que la bactérie développe une résistance à cette stratégie médicamenteuse.
Utiliser les protéines de l'hème (ici HasA ) comme cheval de Troie pour fournir sélectivement des antimicrobiens aux bactéries cibles, permet donc de les éliminer, indépendamment de la résistance qu’elles ont déjà développé aux antibiotiques !
Autres actualités sur le même thème
CICATRICE CHÉLOÏDE: Les promesses de la voie moléculaire
Actualité publiée il y a 9 années 3 moisANTIBIORÉSISTANCE : A chaque patient son histoire, son phénotype et son traitement
Actualité publiée il y a 8 années 3 moisINFECTIONS URINAIRES : L’antibiorésistance favorise la récidive et vice versa
Actualité publiée il y a 7 années 4 moisSOIN des PLAIES: Les soignants et les aidants ont besoin de cicatriser aussi
Actualité publiée il y a 10 années 1 mois




